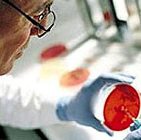

Новости:
 Учёные Израиля, благодаря серьёзным научным изысканиям, наконец, дали надежду на материнство девочкам, которые с детства страдают различными видами онкологических заболеваний.
Учёные Израиля, благодаря серьёзным научным изысканиям, наконец, дали надежду на материнство девочкам, которые с детства страдают различными видами онкологических заболеваний.
Учёные смогли довести до созревания в лабораторных условиях их не половозрелые яйцеклетки, для того чтобы искусственно простимулировать их созревание, а затем заморозить. По мнению исследователей, такая техника даст надежду на материнство страдающим раком и рискующим остаться бесплодными после химиотерапии детям.
Дело в том, что современные методы лечения детских онкологических заболеваний позволяют спасти от 70 до 90% больных детей. В то время как агрессивная химиотерапия, используемая для борьбы с очагами раковой опухоли, часто приводит к тяжелым побочным эффектам, в том числе, к стерильности.
Ранее эту проблему пытались решить с помощью заморозки части ткани яичников и последующей ее имплантации после завершения курса химиотерапии. Однако, поскольку ткани больных могут содержать злокачественные клетки, этот метод значительно увеличивал вероятность рецидивов заболевания.
А благодаря новому способу в будущем замороженные яйцеклетки можно будет использовать для проведения ЭКО в случае, если в результате лечения девочки потеряют возможность забеременеть естественным путем.
Надежда на материнство
Учёные смогли довести до созревания в лабораторных условиях их не половозрелые яйцеклетки, для того чтобы искусственно простимулировать их созревание, а затем заморозить. По мнению исследователей, такая техника даст надежду на материнство страдающим раком и рискующим остаться бесплодными после химиотерапии детям.
Дело в том, что современные методы лечения детских онкологических заболеваний позволяют спасти от 70 до 90% больных детей. В то время как агрессивная химиотерапия, используемая для борьбы с очагами раковой опухоли, часто приводит к тяжелым побочным эффектам, в том числе, к стерильности.
Ранее эту проблему пытались решить с помощью заморозки части ткани яичников и последующей ее имплантации после завершения курса химиотерапии. Однако, поскольку ткани больных могут содержать злокачественные клетки, этот метод значительно увеличивал вероятность рецидивов заболевания.
А благодаря новому способу в будущем замороженные яйцеклетки можно будет использовать для проведения ЭКО в случае, если в результате лечения девочки потеряют возможность забеременеть естественным путем.
| Автор: Nikole |
| 3 июля 2007, 11:00 1545 просмотров |
Единый профиль
МедиаФорт














Комментарии:
Пока нет комментариев.